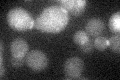
YNR049C
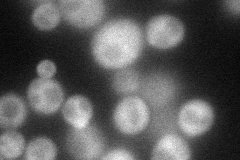
YNR049C
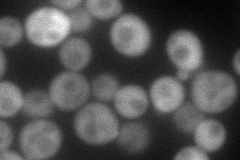
YNR049C
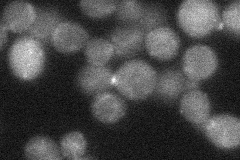
YNR049C
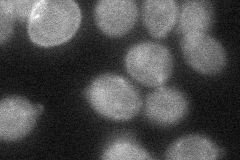
YNR049C
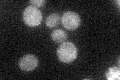
YNR049C

View description
Probable component of the secretory vesicle docking complex, acts at a late step in secretion; shows genetic and physical interactions with Sec1p; required for prospore membrane formation during sporulation
Localization:
Intensity:
Fold change:
Significance:
-
C’ GFP library in SD
bud neckN/A -
N' NOP1pr-GFP in SD
cytosol,bud neck77.794 -
N' TEF2pr-mCherry in SD
cytosol,bud neck97.3641 -
N' NATIVEpr-GFP in SD
punctate,bud26.072 -
N' TEF2pr-VC and Cyto-VN in SD
cytosol36.3423 -
C’ GFP library in SD+DTT

bud neck23.581.3No -
C’ GFP library in SD+H2O2

bud neck16.190.89No -
C’ GFP library in Starvation Media
bud neck30.791.7No -
C’ GFP library on the background of Pup2-DaMP

bud neck -
C’ GFP library on the background of CCT mutant

bud neck16.48870.914711No
